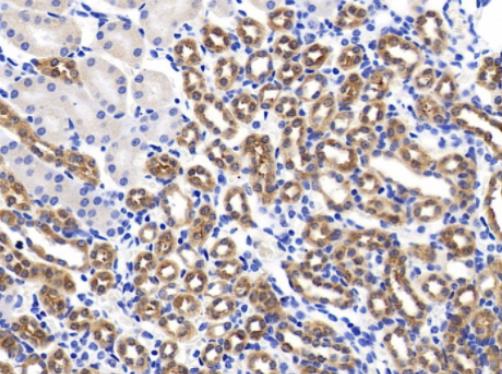
1.png

BCHE(1E8)供应商 更多
上海沪震实业有限公司
联系电话:021-60345367 13916550749
产品介绍:
中文名称:Anti-BCHE(1E8) antibody-丁酰胆碱酯酶单克隆抗体
英文名称:BCHE(1E8)
纯度:> 99%
包装信息:50ul/RMB 1138;100ul/RMB 1880;200ul/RMB 2900
备注:Cholinesterase; Acylcholine acylhydrolase; Choline esterase II
BCHE(1E8)新闻专题 更多
2021-09-09
丁酰胆碱酯酶单克隆抗体的应用